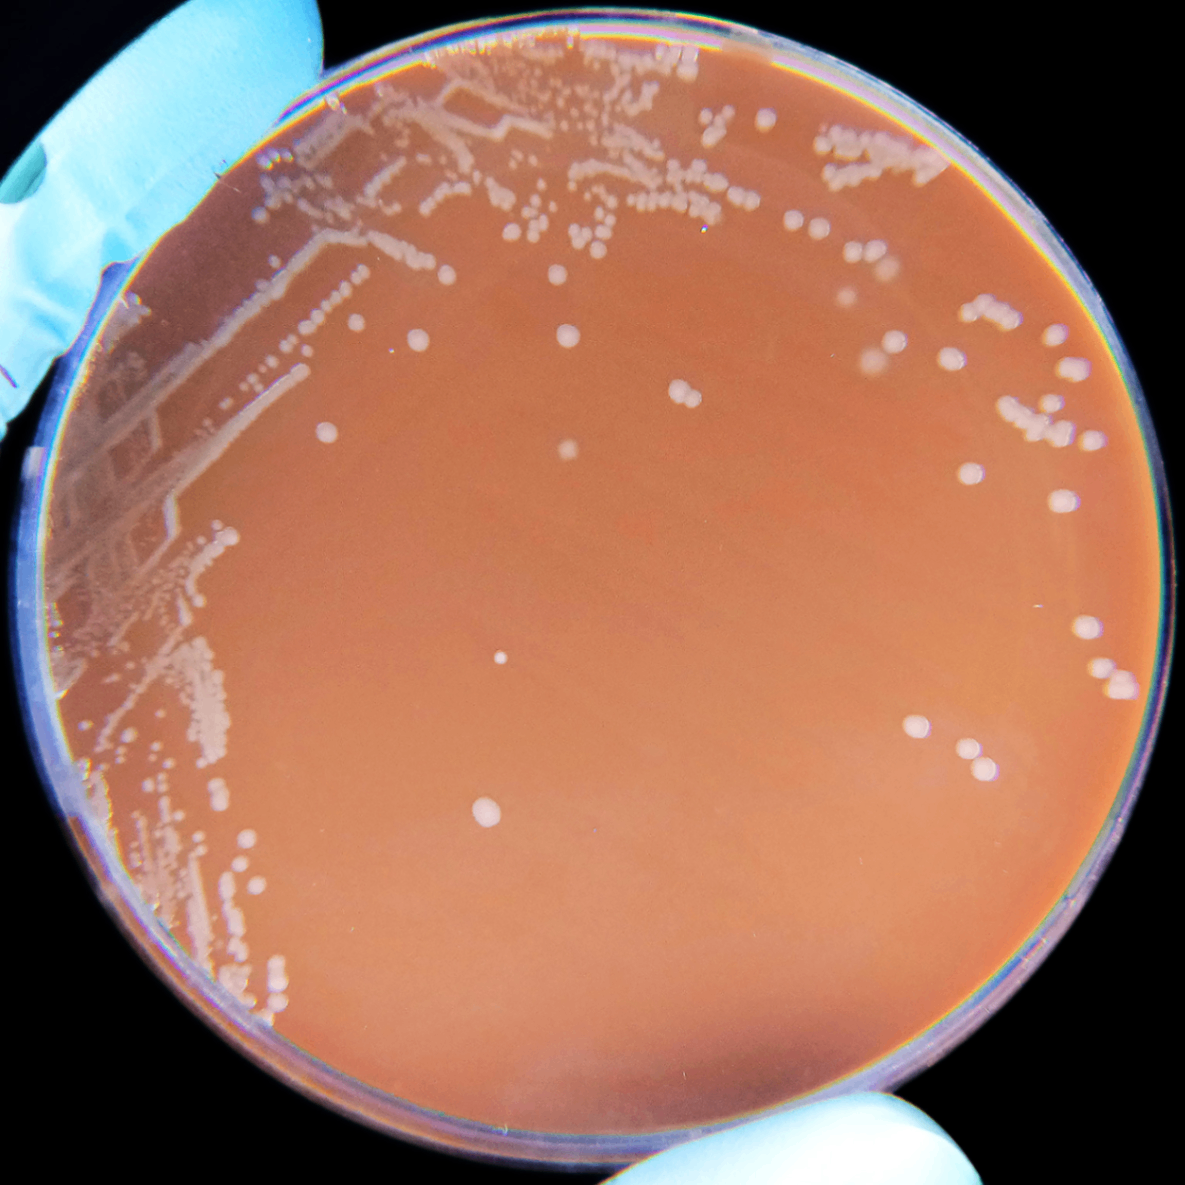

Haemophilus influenzae
이론과 하이라이트 히스토리를 확인 할 수 있어요.
Haemophilus influenzae
: Haemo-(적혈구)+philus(좋아하다). 배양특징과 관계되어 이렇게 이름이 붙었다.
1. 개요
1) 그람음성, 짧은 막대균
2) Normal flora
2. 임상적 특징
1) 협막(capsule) 유형에 따라 분류된다. 그 중 type B가 가장 병원성이 강하여 해당 균(Hib)에 대한 백신이 개발되었다.
2) 소아 수막염, 후두개염, 균혈증 등 중증 감염을 일으킨다.
3) 2세 이하 관절염의 가장 흔한 원인균이다.
3. 배양 특징
: X factor(hemin) 과 V factor(NAD) 필요.
1) Hemin은 다양한 효소의 보조인자로 작용하며, RBC에서 확산되어 배지로 나온다.
2) NAD는 산화-환원 반응에 이용되는 조효소로, RBC가 파괴되어야 배지로 나온다.
3) 상세 설명
: 혈액우무배지에서 V factor가 조금씩 확산되어 나오기는 하지만, NADase가 있어 파괴된다. 따라서 혈액우무배지를 가열했다 식히는 방식을 통해 NADase를 파괴하고 NAD를 적혈구에서 나오게하는데, 이렇게 만든 배지를 초콜릿 우무배지(가열 혈액우무배지)라 한다. 초콜릿 우무배지에서는 Haemophilus influenzae 가 잘 성장할 수 있다.
4) 위성현상
: 혈액우무배지에 S. aureus를 배양하면 β-용혈이 일어나 V factor가 나온다. 따라서 S. aureus 주위에서 H. influenza가 성장한다.